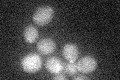
YHR006W
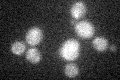
YHR006W

View description
Transcription factor, activated by proteolytic processing in response to signals from the SPS sensor system for external amino acids; activates transcription of amino acid permease genes
Localization:
Intensity:
Fold change:
Significance:
-
C’ GFP library in SD
below threshold15.82 -
N' NOP1pr-GFP in SD

below threshold14.3655 -
N' TEF2pr-mCherry in SD

below threshold4.72795 -
N' NATIVEpr-GFP in SD

below threshold19.7274 -
N' TEF2pr-VC and Cyto-VN in SD

#N/A0 -
C’ GFP library in SD+DTT

cytosol16.521.04No -
C’ GFP library in SD+H2O2
cytosol16.671.05No -
C’ GFP library in Starvation Media

cytosol16.421.03No -
C’ GFP library on the background of Pup2-DaMP

below threshold -
C’ GFP library on the background of CCT mutant

below threshold16.9671.07162No
